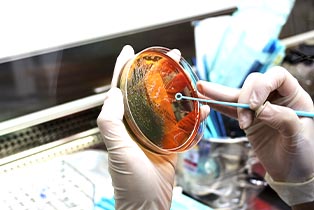
service

At Prognostic Path Lab, we are a trusted diagnostic center in Rajarhat, New Town & Kestopur, Kolkata, offering accurate and timely pathology testing services with reliable results for confident health decisions.
-
Fast. Accurate. Trusted
-
Your Health, Our Mission
-
Caring Through Every Test.
While we believe we are more than just numbers, the depth of our laboratories is pretty impressive.
Find the Right Test for Your Needs!
Your Reliable Health Partner Backed by NABL Certified Standards
Blood Tests
Blood tests are essential tools that help assess your overall health by analyzing various components of your blood. They can detect infections, measure organ function, check nutrient levels, and screen for conditions like diabetes, anemia, and heart disease.

Urine & Stool Tests
Urine and stool tests examine your body's waste products to detect infections, digestive issues, kidney problems, and more. Urine tests can identify urinary tract infections, kidney diseases, and diabetes, while stool tests help find digestive disorders,...

Infection & Immunity Tests
These tests detect the presence of infections caused by bacteria, viruses, or parasites and measure your body's immune response. They are vital for diagnosing conditions like typhoid, dengue, hepatitis, HIV, and COVID-19. Immunity tests also check if you ...

Hormonal & Specialized Tests
Hormonal tests evaluate the levels of various hormones in your body that regulate growth, metabolism, reproduction, and stress. These tests help diagnose thyroid disorders, fertility issues, adrenal gland problems, and other endocrine system conditions, ....

Cytology & Histopathology
Cytology and histopathology involve examining cells and tissue samples under a microscope to diagnose diseases such as infections, inflammations, or cancers. Procedures like Fine Needle Aspiration Cytology (FNAC) and biopsies provide detailed information about ...
Blood Grouping & Compatibility
Blood grouping identifies your blood type (A, B, AB, or O) and Rh factor, which is crucial for safe blood transfusions and pregnancy care. Compatibility tests, such as cross-matching, ensure that donor blood matches the recipient’s, preventing adverse reactions ....

One of the Most Trusted Path Lab in Kolkata!
Renowned for its commitment to accuracy, reliability, and patient care, Prognostic Path Lab has earned a reputation as one of the most trusted diagnostic laboratories in Kolkata.













